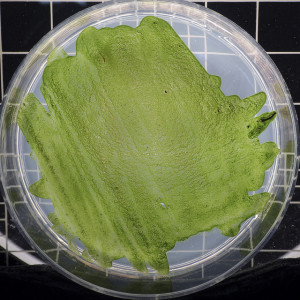
Chlorella tabletta rendelés

Minőségi Chlorella tabletta rendelés
szerző: blogadmin
Chlorella tabletta rendelésA Chlorella alga, akárcsak a Spirulina, a világ egyik leggazdagabb tápanyagforrását képezi. A mikoralgák nagyon egészségesek és az, hogy sikeresen kiállták az idők próbáját, felkeltette az ember érdeklődését. A benne lévő klorofill sokrétű gyógyhatással rendelkezik. A fejlett technológiának köszönhetően, ma már könnyedén hozzáférhetünk ehhez az egyedülálló alga gyógyerejéhez. A Chlorella tabletta rendelés csupán néhány kattintással elérhető. Méregtelenítés és immunerősítés szempontjából is érdemes elkezdeni a rendszeres szedését.
Chlorella tabletta rendelésA Chlorella alga, akárcsak a Spirulina, a világ egyik leggazdagabb tápanyagforrását képezi. A mikoralgák nagyon egészségesek és az, hogy sikeresen kiállták az idők próbáját, felkeltette az ember érdeklődését. A benne lévő klorofill sokrétű gyógyhatással rendelkezik. A fejlett technológiának köszönhetően, ma már könnyedén hozzáférhetünk ehhez az egyedülálló alga gyógyerejéhez. A Chlorella tabletta rendelés csupán néhány kattintással elérhető. Méregtelenítés és immunerősítés szempontjából is érdemes elkezdeni a rendszeres szedését.
A Chlorella tabletta ahogyan bekerül a szervezetbe, természetes módon elkezd kötődni a vegyszerekhez, toxinokhoz, nehézfémekhez, peszticidekhez. Így végzi a nagytakarítást a szervezetben. Szinte mindenféle méreganyag eltávolítható a segítségével. A növekedésben és a fejlődésben is fontos szerepet játszik, így egyértelmű, hogy gyermekek számára is ajánlott a fogyasztása. A Chlorella rendelés jó befektetés az egész család számára, fogyaszthatjuk önmagában, mint étrend kiegészítőt, de megőrölhetjük és az ételekbe is beleszórhatjuk. A Chlorella tabletta rendelés pénz visszafizetési garanciával történik.
Kövess minket RSS-en
